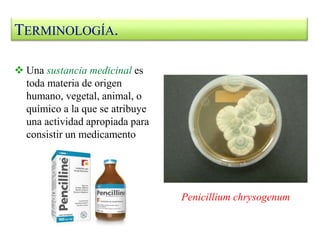
 Una sustancia medicinal es
toda materia de origen
humano, vegetal, animal, o
químico a la que se atribuye
una actividad apropiada para
consistir un medicamento
Penicillium chrysogenum
TERMINOLOGÍA.

El documento proporciona información sobre la farmacognosia. Define la farmacognosia como el estudio de las drogas y sustancias medicamentosas de origen vegetal, animal y microbiano. Explica conceptos clave como planta medicinal, droga vegetal, principio activo y medicamento. También describe los objetivos de la farmacognosia como establecer la composición química de principios activos y obtener extractos de drogas con actividad farmacológica.